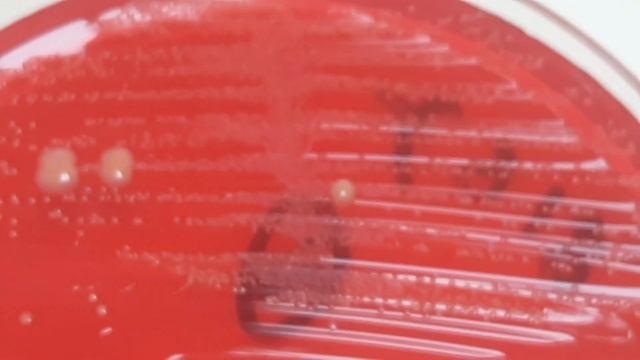
Enterococcus faecalis Colony Morphology on CLED Agar смотреть онлайн

Автор / Канал: Творческий Путь к Саморазвитию Страница 16

??ОЧЕНЬ ВКУСНЫЕ СВИНЫЕ РЁБРЫШКИ НА СКОВОРОДКЕ?️?// ПО ВКУСУ НАПОМИНАЮТ ШАШЛЫК??️

DSCN9833 КРЕЩЕНИЕ ЕВОЧКИ И ВАНЕЧКИ №4

Как и зачем мы делаем коммуникативные книги?

УАЗ патриот 2017 Регулировка сцепления, расход топлива

Как писать ноту "Ре"?

Как сделать кока-колу сода фонтан с 3 различными напитками в домашних условиях

Деймон Таргариен и Дом Дракона: 1 Сезон Разбор Игра Престолов

Как сделать пушку из динамита 100% | майнкрафт

Совсем Взрослая! Как выглядит 12 летняя Внучка Николая Расторгуева! Чудо девочка

Почему ребенок не переворачивается в 6-7 месяцев

Программа, которая все меняет: осанка, походка, грациозность. Елена Ряполова

В бухгалтерии детского садика. Документ без названия на оплату, а есть ли долг?

?СВЕТОФОР?ТОП?ЛУЧШИХ ТОВАРОВ?Это БЕРУТ ЧАЩЕ?Покажу самые покупаемые товары✅️Январь 2023

Как же забиндить шипы на cristalix & Custom Steve Chaos
Enterococcus faecalis Colony Morphology on CLED Agar

Занятия танцами в детском центре «Мама и Я» для детей от 3 лет

Зоопарк в Норвегии / Первый наш влог / Часть 1

Монтирование дисковых разделов в Linux командой mount

3 Способа сделать конус. Один лучше другого!

История профессии - библиотекарь

ЕВГЕНИЙ СПИЦЫН О НОБЕЛЕВСКОМ ЛАУРЕАТЕ МУРАТОВЕ

Игорь Кравченко | Обществознание: график спроса и предложения, вопрос 21 из ЕГЭ

КИСЕЛЬ !!!!!!! КАК МНОГО В ЭТОМ СЛОВЕ. !!!!!

Урок 2 - Персонаж, Земля, Трава... Как создать свою игру в Construct 2?
За каждым успешным каналом стоит личность, идея и сотни часов кропотливого труда. Если вы здесь, значит, автор «Творческий Путь к Саморазвитию» уже сумел зацепить ваше внимание своим уникальным стилем или подачей. А мы на RUVIDEO позаботились о том, чтобы вы могли изучить весь архив его работ в максимально комфортных условиях — без лишней суеты и преград.
Почему за работами канала «Творческий Путь к Саморазвитию» так интересно наблюдать? Всё просто: это честный контент, который находит отклик в сердцах зрителей. На нашем ресурсе вы можете смотреть онлайн все видео любимого автора бесплатно и в хорошем качестве. Нам важно, чтобы вы видели каждую деталь и слышали каждый нюанс, поэтому мы используем только стабильные плееры из открытых источников Rutube.
Следите за новинками канала, пересматривайте старые шедевры и открывайте для себя новые грани творчества «Творческий Путь к Саморазвитию». Мы постоянно обновляем ленту, чтобы у вас под рукой всегда были самые свежие выпуски. Никаких сложных регистраций — только вы и творчество, которое вдохновляет. Приятного вам путешествия по миру авторского контента на RUVIDEO!
Видео взято из открытых источников Rutube. Если вы правообладатель, обратитесь к первоисточнику.